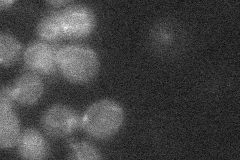
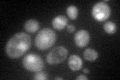

View description
cAMP-dependent protein kinase catalytic subunit; promotes vegetative growth in response to nutrients via the Ras-cAMP signaling pathway; inhibited by regulatory subunit Bcy1p in the absence of cAMP; partially redundant with Tpk2p and Tpk3p
Localization:
Intensity:
Fold change:
Significance:
-
C’ GFP library in SD

nucleus:cytosol33.6 -
N' NOP1pr-GFP in SD
below threshold12.7928 -
N' TEF2pr-mCherry in SD

missing0 -
N' NATIVEpr-GFP in SD

below threshold20.7153 -
N' TEF2pr-VC and Cyto-VN in SD

#N/A0 -
C’ GFP library in SD+DTT

nucleus.cytosol38.031.13No -
C’ GFP library in SD+H2O2

nucleus.cytosol43.071.28No -
C’ GFP library in Starvation Media
nucleus,cytosol92.232.74Yes -
C’ GFP library on the background of Pup2-DaMP

nucleus:cytosol -
C’ GFP library on the background of CCT mutant

nucleus:cytosol32.81560.976521No
